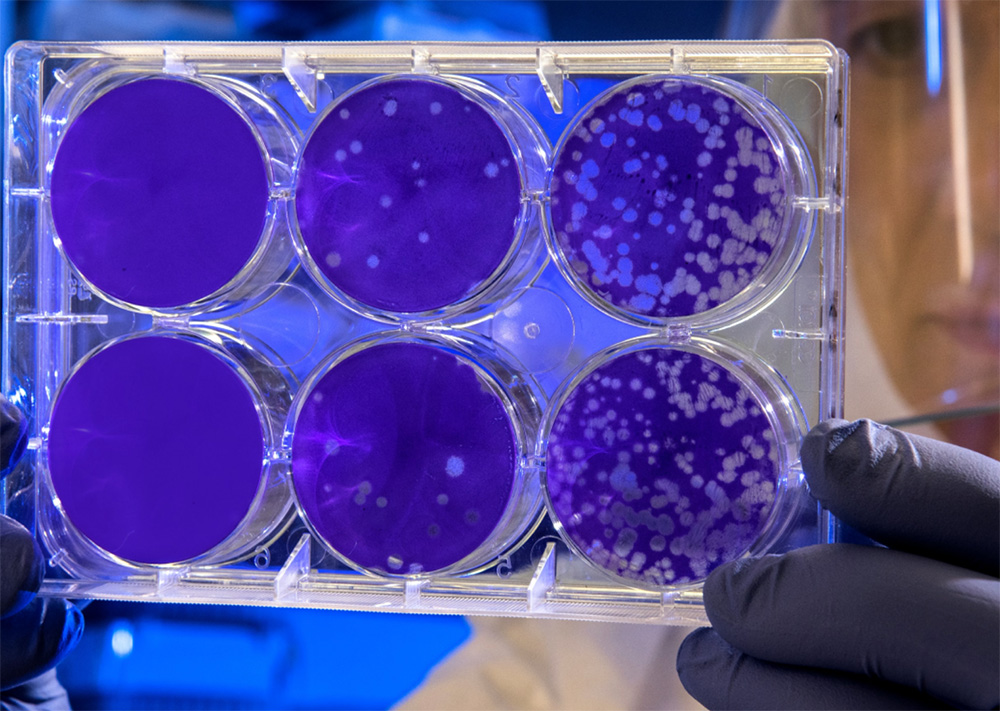
En este momento estás viendo Cultivo celular marino y en polvo… alimentando al mundo desde Portugal.

Una startup portuguesa lidera un proyecto europeo para el cultivo de proteínas marinas.
Una de las startups que más me han llamado la atención este año es la portuguesa Cell4Food. Su propuesta es la del cultivo de células de peces, moluscos y crustáceos para la elaboración de una proteína de consumo humano. Hasta aquí nada nuevo. La novedad radica en su capacidad para la transformación de esta proteína en un polvo que luego puede ser texturizado o incluso utilizado en impresión 3D.
Cell4Food está situada en Matosinhos una pequeña población portuguesa a escasos 100 km. de nuestra frontera norte. Desde aquí lideran un proyecto, pionero en Europa, de nombre CellBlue para el desarrollo de proteínas mediante el cultivo celular. Su tecnología no invasiva extrae células de pequeños animales marinos para su duplicación y crecimiento en biorreactores. Mediante tecnología desarrollada por ellos mismos, convierten la biomasa resultante en un polvo viable para la elaboración de alimentos en estado sólido.
Un proyecto que todavía está siendo desarrollado y que cuenta con colaboración institucional y privada. El objetivo es el desarrollo de una proteína alimentaria de origen marino con perfiles nutricionales específicos y a la carta. Totalmente sostenible y segura en términos de seguridad alimentaria.
Sigo atento y estoy seguro que oiremos hablar y muy bien de Cell4Food en breve.